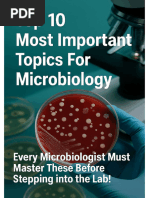

Tools of the Laboratory:
The Methods for Studying
Microorganisms
1. Inoculation introduction of a sample into a
container of media to produce a culture of
observable growth
2. Isolation separating one species from
another
3. Incubation under conditions that allow
growth
4. Inspection
5. Identification
2
If an individual bacterial cell is separated
from other cells and has space on a
nutrient surface, it will grow into a mound
of cells - a colony.
A colony consists of one species.
3
4
Insert figure 3.2
Isolation technique
Isolation techniques include:
streak plate technique
pour plate technique
spread plate technique
5
6
Insert figure 3.3
Isolation methods
Media can be classified according to three
properties:
1. Physical state liquid, semisolid and solid
2. Chemical composition synthetic
(chemically defined) and nonsynthetic
(complex)
3. Functional type general purpose,
enriched, selective, differential, anaerobic,
transport, assay, enumeration
7
Liquid broth; does not solidify
Semisolid clot-like consistency; contains
solidifying agent (agar or gelatin)
Solid firm surface for colony formation
contains solidifying agent
liquefiable and nonliquefiable
8
Most commonly used solidifying agent is agar
(a complex polysaccharide isolated from red
algae)
solid at room temp, liquefies at boiling (100
o
C),
does not resolidify until it cools to 42
o
C
provides framework to hold moisture and
nutrients
not digestible for most microbes
9
Most commonly used media:
nutrient broth liquid medium containing
beef extract and peptone
nutrient agar solid media containing beef
extract, peptone and agar
10
Synthetic contains pure organic and
inorganic compounds in an exact
chemical formula
Complex or nonsynthetic contains at
least one ingredient that is not
chemically definable
General purpose media- grows a broad
range of microbes, usually nonsynthetic
11
Enriched media- contains complex organic
substances such as blood, serum, hemoglobin or
special growth factors required by fastidious
microbes
Selective media- contains one or more agents
that inhibit growth of some microbes and
encourage growth of the desired microbes
Differential media allows growth of several
types of microbes and displays visible differences
among desired and undesired microbes
12
13
Reducing medium contains a substance
that absorbs oxygen or slows penetration of
oxygen into medium; used for growing
anaerobic bacteria
Carbohydrate fermentation medium
contains sugars that can be fermented,
converted to acids, and a pH indicator to
show the reaction; basis for identifying
bacteria and fungi
14
15
Insert figure 3.10
Differential media
Incubation temperature-controlled chamber
at appropriate temperature and atmosphere
microbe multiplies and produces macroscopically
observable growth
Inspection observation; macroscopic and
microscopic
pure culture grows only single known species of
microorganisms
mixed cultures hold two or more identified
species or microorganisms
contaminated culture once pure or mixed
culture that has unwanted microbes growing
16
Identification macroscopic and
microscopic appearance, biochemical
tests, genetic characteristics,
immunological testing
17
Potentially hazardous cultures and
specimens are usually disposed of in two
ways:
steam sterilization
incineration
18
Key characteristics of a reliable microscope
are:
Magnification ability to enlarge objects
Resolving power ability to show detail
19
Magnification in most microscopes results
from interaction between visible light
waves and curvature of the lens.
angle of light passing through convex surface of
glass changes refraction
Depending on the size and curvature of the lens,
the image appears enlarged.
extent of enlargement - magnification
20
21
Insert figure 3.14
Student microscope
Magnification occurs in two phases
The objective lens forms the magnified real image.
The real image is projected to the ocular where it is
magnified again to form the virtual image.
Total magnification of the final image is a
product of the separate magnifying powers of
the two lenses.
power of objective X power of ocular = total
magnification
22
23
Insert figure 3.15
Pathway of light
Resolution defines the capacity to distinguish
or separate two adjacent objects resolving
power
function of wavelength of light that forms the
image along with characteristics of objectives
Visible light wavelength is 400 nm 750 nm.
Numerical aperture of lens ranges from 0.1 to 1.25.
Oil immersion lens requires the use of oil to prevent
refractive loss of light.
Shorter wavelength and larger numerical aperture will
provide better resolution.
Oil immersion objectives resolution is 0.2 m.
Magnification between 40X and 2000X
24
25
Insert figure 3.16
Wavelength on resolution
26
Insert figure 3.17
Oil immersion lens
Bright-field most widely used; specimen is
darker than surrounding field; live and
preserved stained specimens
Dark-field brightly illuminated specimens
surrounded by dark field; live and unstained
specimens
Phase-contrast transforms subtle changes in
light waves passing through the specimen into
differences in light intensity, best for
observing intracellular structures
27
28
Modified compound microscope with an
ultraviolet radiation source and a filter that
protects the viewers eye
Uses dyes that emit visible light when
bombarded with shorter UV rays - fluorescence
Useful in diagnosing infections
29
30
Insert figure 3.21
Fluorescent staining
Forms an image with a beam of electrons that
can be made to travel in wavelike patterns
when accelerated to high speeds
Electron waves are 100,000 times shorter than
the waves of visible light.
Electrons have tremendous power to resolve
minute structures because resolving power is a
function of wavelength.
Magnification between 5,000X and 1,000,000X
31
Transmission electron microscopes (TEM)
transmit electrons through the specimen.
Darker areas represent thicker, denser parts
and lighter areas indicate more transparent,
less dense parts.
Scanning electron microscopes (SEM) provide
detailed three-dimensional view. SEM
bombards surface of a whole, metal-coated
specimen with electrons while scanning back
and forth over it.
32
33
Insert figure 3.24b
Transmission micrograph
34
Insert figure 3.25
Scanning micrographs
Wet mounts and hanging drop mounts
allow examination of characteristics of live
cells: motility, shape, and arrangement
Fixed mounts are made by drying and
heating a film of specimen. This smear is
stained using dyes to permit visualization
of cells or cell parts.
35
Dyes create contrast by imparting a color to
cells or cell parts.
Basic dyes - cationic, with positive
charges on the chromophore
Acidic dyes - anionic, with negative
charges on the chromophore
Positive staining surfaces of microbes
are negatively charged and attract basic
dyes
Negative staining microbe repels dye,
the dye stains the background
36
Simple stains one dye is used; reveals
shape, size, and arrangement
Differential stains use a primary stain
and a counterstain to distinguish cell types
or parts (examples: gram stain, acid-fast
stain and endospore stain)
Special stains reveal certain cell parts not
revealed by conventional methods: capsule
and flagellar stains
37
38
Insert figure 3.27
Types of stains